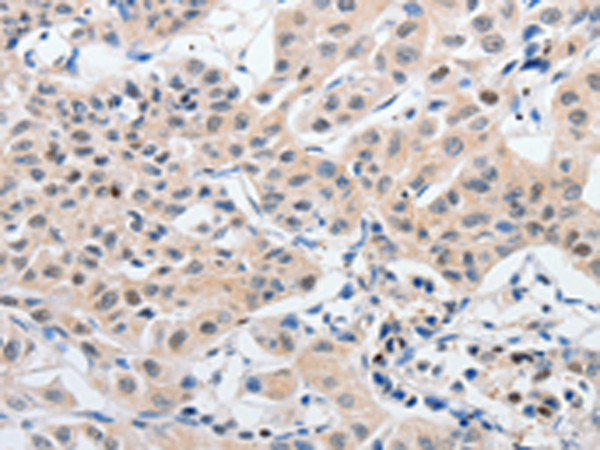

-
分类: 科研抗体货号: P11078别名: P2Y6应用: WB,IHC反应种属: Human, Mouse, Rat
-
分类: 科研抗体货号: P11056别名: UVO; CDHE; ECAD; LCAM; Arc-1; BCDS1; CD324应用: WB,IHC反应种属: Human, Mouse, Rat
-
分类: 科研抗体货号: P11077别名: P2Y1应用: WB,IHC反应种属: Human, Mouse, Rat
-
分类: 科研抗体货号: P11054别名: 1C5, HS1, 14-3-3应用: WB,IHC反应种属: Human, Mouse, Rat
-
分类: 科研抗体货号: P11076别名: OX2R应用: IHC反应种属: Human, Mouse, Rat
-
分类: 科研抗体货号: P11053别名: 14-3-3GAMMA应用: WB,IHC反应种属: Human, Mouse, Rat
-
分类: 科研抗体货号: P11072别名: EB11, NR2D, GluN2D, NMDAR2D应用: IHC反应种属: Human, Mouse, Rat
-
分类: 科研抗体货号: P11087别名: CD31, PECA1, GPIIA', PECAM-1, endoCAM, CD31/EndoCAM应用: WB,IHC反应种属: Human, Mouse
-
分类: 科研抗体货号: P11071别名: NR2C, GluN2C, NMDAR2C应用: IHC反应种属: Human
-
分类: 科研抗体货号: P11086别名: ALL3; BSAP应用: WB,IHC反应种属: Human, Mouse, Rat

鄂公网安备42018502007531号
鄂公网安备42018502007531号

